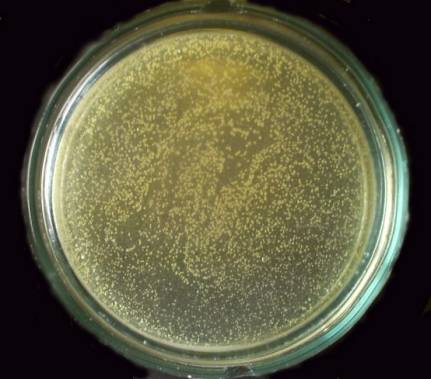
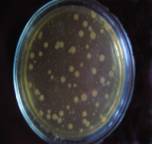
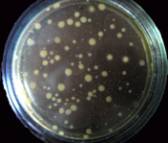
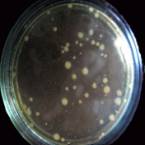

к.б.н.
Круталевич А.А.
ст.преподаватель
Досмухамбетов А.Ж.
магистр
ветеринарныхнаук Асанова Д.Д.
Костанайский
государственный университет имени А.Байтурсынова, Казахстан
Улучшение гигиенических условий содержания
животных путем использования эффективных
видов подстилочных материалов
Важной задачей при производстве
молока является повышение его санитарного качества, это проблема особенно
актуальна перед вступлением Республики Казахстан в всемирную торговую
организацию (ВТО). Достичь этого без организации комплекса ветеринарных и
санитарно-гигиенических мероприятий, обеспечивающих производство
высококачественного молока невозможно.
Высокая микробная обсемененность молока остается серьезной проблемой для молокопроизводителей и является основным критерием оценки санитарных условий его получения. К основным требованиям от которых зависит санитарное качество молока, относятся: содержание животных в чистоте, тщательная санитарная обработка вымени до и после доения, систематический контроль за состоянием здоровья животного и вымени, наличие систематического ухода за сосками вымени и их санитарная обработка, чистота доильной аппаратуры и молочной посуды, чистота рук доярок и т.д.
Важным моментом получения молока высокой чистоты является содержание животных в хороших гигиенических условиях, обеспечивающих санитарную чистоту кожного покрова. Для улучшения гигиенических условий содержания животных, и, прежде всего, санитарного состояния пола, нами были использованы и изучены с точки зрения санитарно-гигиенических характеристик, различные виды подстилочных материалов: солома, опилки опилки в сочетании с природными минералами, обладающими бактерицидными свойствами (цеолиты).
Известно, что цеолиты, благодаря
особенностям кристаллического строения обладают уникальными адсорбционными,
ионообменными свойствами. Они способны поглощать разные газы, характеризуются
термостабильностью, достаточной механической прочностью и антибактериальными
свойствами. Поэтому перед нами была поставлена задача изучить не
только гигиенические характеристики используемых подстилочных материалов, но и
разработать способы повышения их эффективности в санитарно-гигиеническом плане,
путем добавления к ним небольших количеств природных минералов. Причем цеолиты
добавляли, в основном, со стороны задней
части стойла.
С
целью определения влияния санитарного состояния пола на загрязненность кожного
покрова животных были проведены научно-производственные
опыты с использованием подстилочных материалов с
разным составом.
Во
всех опытных группах подстилка полностью менялась каждый день, стойла
просушивали, а затем вносили свежие подстилочные
материалы. Пробы на микробные загрязнения поверхности кожных покровов
животных брали ежедневно 2 раза: после замены подстилки через 12часов и 24часа.
Полученные результаты исследований по изучению эффективности различных составов
подстилочных материалов представлены в таблице 1 и на рисунках 1-5.
Как видно из данных таблицы, во всех опытах количество микроорганизмов в различных участках поверхности кожи значительно в 1,5-2,5 раза снизилось по сравнению с контролем. При этом наибольшее снижение загрязненности поверхности кожи по количеству микроорганизмов наблюдается в опыте №4 (опилка+цеолит 10%), где снижение количества микроорганизмов составило с поверхности кожи вымени с 227±1,8 до 42±0,4 тыс. КОЕ/ см2 или 18%, а с поверхности кожи сосков - с 41,0±0,2 до 12,0±0,2.тыс. КОЕ/ см2 или 29%.
Таблица 1 - Влияние различных подстилочных
материалов на санитарное состояние
кожного покрова животных n = 5
|
Вид подстилочного материала |
Кол-во микробных тел на поверхности кожного покрова, тыс.КОЕ/ см 2 (М+m) |
|
Кожа вымени
|
Кожа сосков |
|
|
Контроль |
227,0±1,8 |
41,0±0,2 |
|
Солома (опыт №1) |
116,0±0,2. |
21,0±0,4 |
|
Опилка (опыт №2) |
112±0,2 |
16,0±0,2 |
|
Опилка + 5% цеолит (опыт №3) |
55±1,6 |
15,0±0,2 |
|
Опилка + 10% цеолит (опыт №4) |
42±0,4 |
12,0±0,2 |
А
Рисунок 1 – Рост микроорганизмов на поверхности кожного
покрова
А – контроль, Б – опыт 1, В – опыт 2, Г – опыт 3, Д –
опыт 4

Б
В
Г
Д
Таким образом, можно сделать заключение, что применение подстилочных
материалов значительно улучшает санитарное состояние кожного покрова животных. Лучшие
условия содержания животных установлены при использовании опилок в количестве 3-5кг, а добавление природных минералов (цеолитов) к подстилочным материалам (до 10% от общего
объема) позволило заметно снизить
микробную загрязненность кожи вымени (в 1,5-2 раза). Следовательно, применение ежедневно сменяемых подстилок с добавлением
природных минералов способствует снижению микробной загрязненности, улучшению
санитарно-гигиенического состояния пола и, в целом, улучшению
санитарно-гигиенических условий содержания животных.
Литература
1 Барановский М.В.
Влияние разных способов обработки
вымени коров на санитарно-гигиеническое качество молока // Науч.основы развития
животнов. БССР: Межвед. сб., 1985. – Вып.
15. – С. 97-101.
2 Белоусов В.И., Демидова Л.Д.,
Миляновский А.Г., Ивановцев В.В. Санитария производства молока // Ветеринария.
– 2002. - №5. - С. 3-6
3
Барабанщиков Н.В. Качество молока и молочных продуктов. – М.: Агропромиздат,
1980. – 254с.
4 Варганов А.И., Конопельцев И.Г.,
Бояренцев Л.Е. Диагностика скрытого мастита у коров // Ветеринария. – 1991. -
№11. - С.44-45.
5. Слободяник В.И.,
Ческидова Л.В., Терентьева Т.Н. Аутоимунные процессы в организме коров при акушерской патологии //
Ветеринария № 2, 2000. - С.35-41.